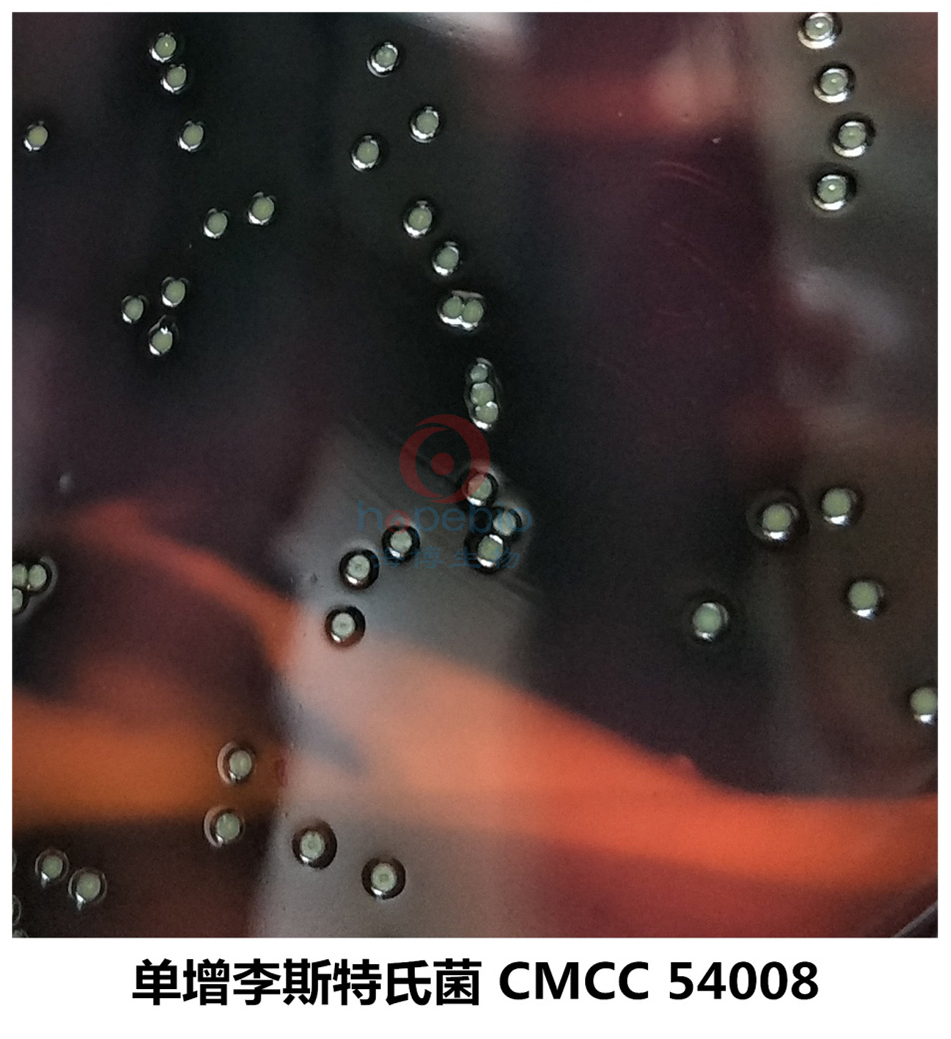
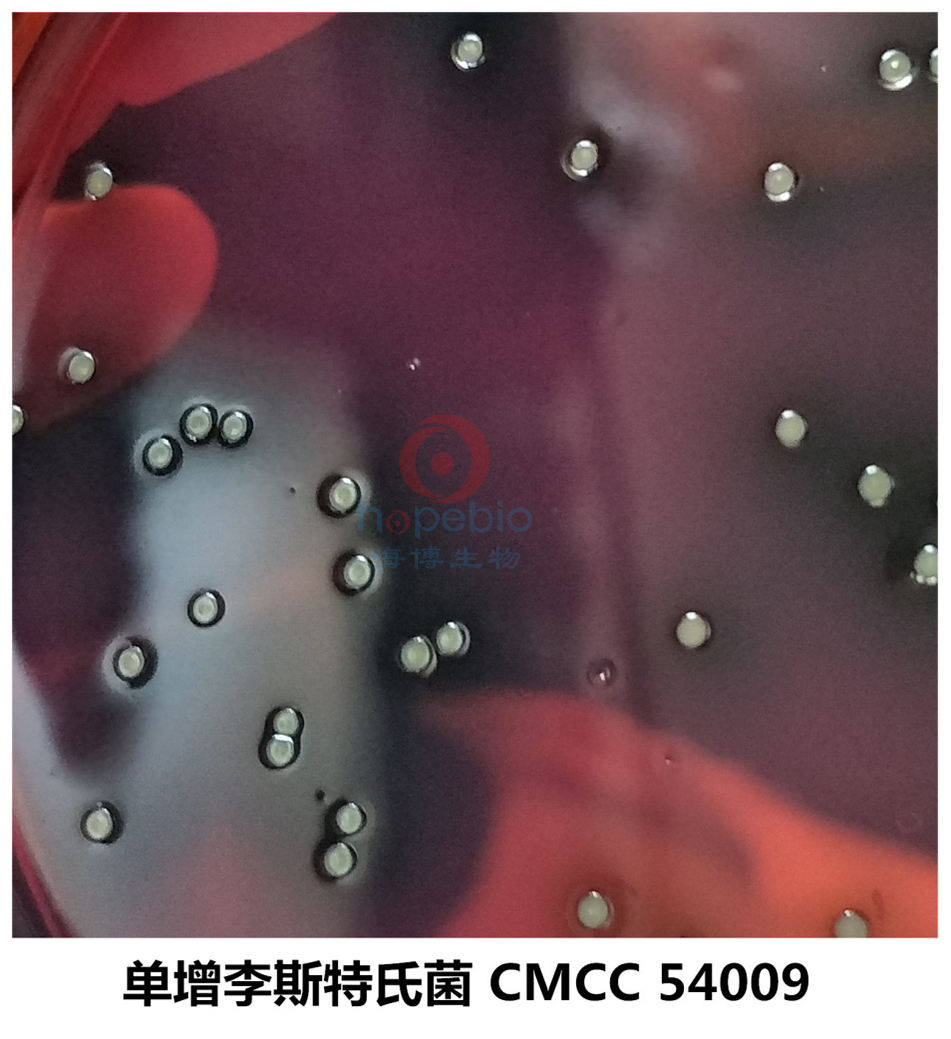

海博微信公众号
海博微信公众号
 海博天猫旗舰店
海博天猫旗舰店


 海博微信公众号
海博微信公众号
 海博天猫旗舰店
海博天猫旗舰店




一、引言
单核细胞增生李斯特氏菌是一种人畜共患病的病原菌,李斯特氏菌中毒严重的可引起血液和脑组织感染,感染后主要表现为败血症、脑膜炎和单核细胞增多。它广泛存在于自然界中,食品中存在的单增李氏菌对人类的安全不利,该菌在4℃的环境中仍可生长繁殖,是冷藏食品威胁人类健康的主要病原菌之一,因此,在食品卫生微生物检验中,必须加以重视。目前,很多国家已经采取措施来控制食品中的李斯特氏菌,并制定了相应的标准。2001年11月以来,中国质检部门多次从美国、加拿大、法国、爱尔兰、比利时、丹麦等二十多家肉类加工厂进口的猪腰、猪肚、猪耳、小排等三十多批近千吨猪副产品中检出单增李斯特氏菌。
二、单增李斯特氏菌简介
单增李斯特氏菌为革兰氏阳性短杆菌,大小约为0.5μmх1.0-2.0μm,直或稍弯,两端钝圆,常呈V字型排列,偶有球状、双球状,兼性厌氧、无芽孢,一般不形成荚膜,但在营养丰富的环境中可形成荚膜,在陈旧培养基中的菌体可呈丝状,该菌有4根周毛和1根端毛,但周毛易脱落。
该菌的生长范围为2-42℃(也有报道在0℃能缓慢生长),最适培养温度为35-37℃,在pH中性至弱碱性(pH9.6)的条件下生长良好。在固体培养基上,菌落初始很小,透明,边缘整齐,呈露滴状,但随着菌落的增大,变得不透明。在5-7%的血平板上,菌落通常也不大,灰白色,接种血平板培养后可产生窄小的β-溶血环。在0.6%酵母浸膏胰酪大豆琼脂(TSA-YE)上,用450角入射光照射菌落,菌落呈蓝色、灰色或兰灰色。
三、单增李斯特氏菌的控制
该菌对理化因素抵抗力较强,在土壤、粪便、青储饲料和干草内能长期存活,对碱和盐抵抗力强,60-70℃经5-20min可杀死,70%酒精5min、2.5%石炭酸、2.5%氢氧化钠、2.5%福尔马林20min 可杀死此菌。该菌对青霉素、氨苄青霉素、四环素、磺胺均敏感。
单增李斯特氏菌在一般热加工处理中能存活,热处理已杀灭了竞争性细菌群,使单增李斯特氏菌在没有竞争的环境条件下更易于存活,所以在食品加工中,中心温度必须达到70℃持续2分钟以上。单增李斯特氏菌在自然界中广泛存在,所以即使产品已经过热加工处理充分灭活了单增李斯特氏菌,但有可能造成产品的二次污染,因此蒸煮后防止二次污染是极为重要的。由于单增李斯特氏菌在4℃下仍然能生长繁殖,所以未加热的冰箱食品增加了食物中毒的危险,冰箱冷藏的食品需加热后再食用。
四、单增李斯特氏菌检测用的PALCAM琼脂
GB4789.30-2016食品安全国家标准 食品微生物学检验 单核细胞增生李斯特氏菌检验 中PALCAM琼脂为必选的选择性分离培养基,选择性强,可抑制革兰氏阴性菌和粪肠球菌。

有关该培养基的成分及使用方法,请参考:点击查看产品详情
有关该培养基的原理和使用注意事项,请参考:点击查看相关文章
五、全面试验情况
为了进一步验证该培养基的有效性,自本实验室中选取7株单增李斯特氏菌在TSB肉汤中活化后接种于PALCAM琼脂平板,36℃±1℃培养24h-48h观察不同单增李斯特氏菌的菌落形态是否典型。
具体选取的单增李斯特氏菌菌株如下:
|
菌株编号 |
菌株名称 |
|
ATCC 19115 |
单增李斯特氏菌 |
|
CMCC 54008 |
单增李斯特氏菌 |
|
CMCC 54009 |
单增李斯特氏菌 |
|
CMCC 54010 |
单增李斯特氏菌 |
|
CMCC 54011 |
单增李斯特氏菌 |
|
CMCC 54012 |
单增李斯特氏菌 |
|
CICC 21583 |
单增李斯特氏菌 |
经观察,以上7株单增李斯特氏菌培养后为灰绿色圆形菌落,凹陷,有黑色中心,菌落周围呈黑色,直径1-3mm,不同菌株的菌落形态略有差异,但都呈现出典型特征,回收率均在80%以上
具体单增李斯特氏菌的菌落特征参考下图:
 |
|
|
|
|
|

|
|
|
|
 |
 |
|
|
|
|
本培养基要求抑制大肠埃希氏菌和革兰氏阳性菌-粪肠球菌,避免对李斯特氏菌的检出产生干扰,故自实验室中选取6株大肠埃希氏菌和7株粪肠球菌进行验证。分别取1μL菌液半定量划六线,36℃培养40h后计数生长指数G值,结果如下:
非目标菌株在PALCAM琼脂培养基上的生长情况
|
PALCAM琼脂培养基(产品号:HB4188)平板上生长的7株单增李斯特氏菌的菌落形态呈现典型的菌落特征:灰绿色圆形菌落,凹陷,有黑色中心,菌落周围呈黑色,直径1-3mm,回收率均高于80%,符合标准回收率大于70%的要求,13株非目标菌均被抑制,综合考虑,本培养基的性能良好,可有效检出样品中的目标菌。
六、注意事项
在进行李斯特氏菌检测的过程中,同时需要与李斯特氏菌显色培养基上分离的典型和可疑菌落纯化后进行后续的生化与血清学鉴定,综合分析判断是否为李斯特氏菌。
参考文献:
[1]GB 4789.28-2013 食品微生物学检验 培养基和试剂的质量要求.
[2]GB 4789.30-2016 食品安全国家标准 食品微生物学检验 单核细胞增生李斯特氏菌检验.
注:本文属海博生物原创,未经允许不得转载。
上一篇:接菌后平板上无菌生长的原因解析
下一篇:实验室常用灭菌方式介绍及应用



